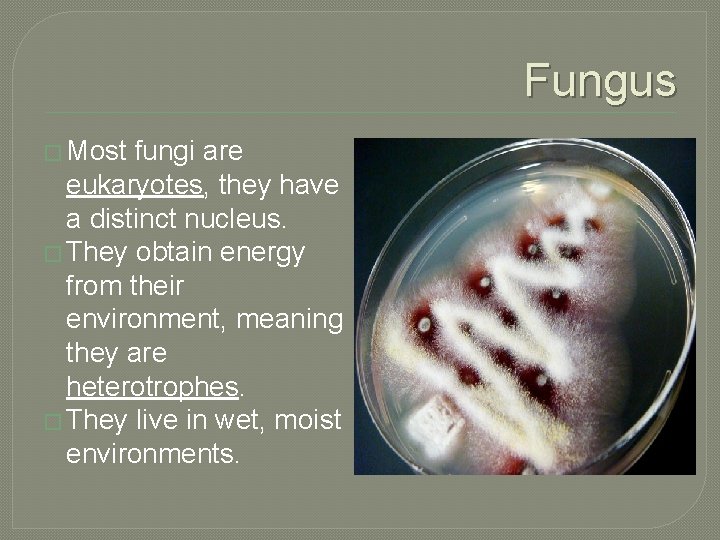
Fungus � Most fungi are eukaryotes, they have a distinct nucleus. � They obtain

Types of Pathogens Describe the characteristics of different

Types of Pathogens • Describe the characteristics of different types of pathogens. • Classify pathogens by their characteristics.

Viruses � Viruses are a tiny, nonliving particle that enters and then reproduces inside a living cell. � A virus is composed of genetic material (DNA or RNA) inside a protein coat.


Viruses � Viruses are specific to certain host cells. � A bacteriaphage is a virus that infects bacteria. � A virus must infect a host cell in order to use the cells materials to reproduce more viruses. � Viruses can cause disease.

Viruses � Active vs. Hidden viruses • Active viruses multiply immediately after injecting its genetic material into the host cell. Example- Influenza virus • Hidden viruses can wait to multiply even after injecting its genetic material into the host. Example- Cold Sore

Viruses � Diseases caused by viruses include: � Influenza, polio, chicken pox, Ebola, and AIDS � � Treatments: antiviral medications �

Viruses

Bacteria are single celled organisms but can form chains or clumps of independent cells. � Shapes include rod, sphere, and spiral. � They are prokaryotes, the genetic material is not found in a nucleus, but floats freely in the cytoplasm. � Bacteria do NOT contain organelles other than ribosome’s. �

Bacteria � Bacteria can reproduce through sexual and asexual reproduction. • Asexual- called Binary fission- A cell first duplicates its genetic material and then divides into two identical cells. • Sexual- called Conjugation - Bacterium transfers some of its genetic material into another bacterium through a thin, threadlike bridge that joins the two cells.

Bacteria may have simple, single stranded flagella that rotates and allows the bacteria to move. � Bacteria can cause disease but are also useful in oxygen and food production, environmental recycling and medicine production. � Antibiotics are chemicals that kill bacterial cells. �

Bacteria � Examples: : Rabies, Lyme Disease and Leprosy. � Treatments: antibiotics such as Penicillin, amoxicillin, or others

Protist Most protists are single celled organisms, but some are multi cellular. � Protists are eukaryotes; they have a distinct nucleus containing genetic material. � Protists may contain flagella or cilia that allow the cell to move. Some contain pseudopods which are temporary bulges of the cell used for movement and trap food. �

Protists Many Protists are carried by a vector, a carrier of a disease that passes it on to a human host ie. mosquito, tick. � Diseases caused by Protists include: Malaria (Plasmodia) � Amoebic Dysentery (Entamoeba histolytica) � Giardiasis (Giardia lamblia) � Treatment of Protozoan infectious: �
Fungus � Most fungi are eukaryotes, they have a distinct nucleus. � They obtain energy from their environment, meaning they are heterotrophes. � They live in wet, moist environments.

Fungus � Reproduction: They reproduce through both sexual and asexual reproduction. • Asexual reproduction- similar to mitosis and binary fission certain fungi go through budding or create spores. • Sexual reproduction- fungi will exchange DNA and produce spores with the new DNA.

Fungus � Examples of Fungal infections are ringworm, and Athlete’s foot (Tinea). � Treatments include antifungal medications.

Classwork 1. Using the Cards at your desk classify each microorganism based on their description. Virus Bacteria Protist
- Slides: 17